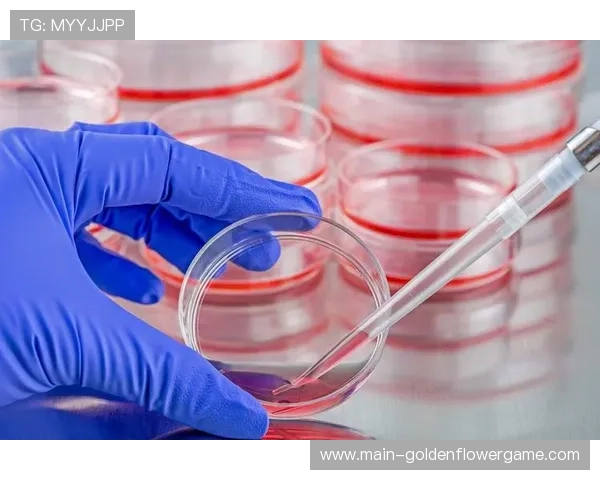
分析师展望《eFootball™》手机组决赛：操作精度成胜负关键

分析师展望《eFootball™》手机组决赛:操作精度成胜负关键
《eFootball™》手机组决赛即将在全球电竞舞台上拉开帷幕,吸引了众多电竞爱好者的关注。比赛地点设在东京,这座城市以其先进的技术设施和浓厚的电竞氛围闻名。此次决赛不仅是对选手技术水平的考验,更是对他们心理素质和团队协作能力的全面检验。随着赛事的临近,各队伍纷纷进入最后的备战阶段,力求在操作精度上取得突破,以争夺最终的荣耀。分析师们普遍认为,操作精度将成为本次决赛胜负的关键因素。如何在高压环境下保持稳定发挥,是每位选手必须面对的挑战。在这场巅峰对决中,谁能在关键时刻展现出更高的操作精度,谁就有可能笑到最后。
1、选手操作精度与战术执行
在《eFootball™》手机组决赛中,选手们面临的不仅是对手的挑战,还有来自自身操作精度的考验。高水平的操作精度是成功执行战术策略的基础,而这正是每支队伍在备战过程中重点关注的领域。为了提升操作精度,各队伍纷纷加强训练,通过模拟比赛环境来提高选手在实际比赛中的反应速度和准确性。
同时间段内,各队教练也在不断调整战术,以适应选手们不同风格和特点。教练们通过分析过往比赛数据,发现控球率提升至70%能够有效增加进攻机会。这一数据为教练们制定更具针对性的战术提供了重要参考,使得选手们能在比赛中更好地发挥个人技术。
然而,操作精度不仅仅依赖于训练,还受到心理状态的影响。在高强度比赛中,选手们需要保持冷静和专注,以避免因心理压力导致失误。这也意味着心理辅导成为备战的重要组成部分,通过专业心理辅导员的帮助,选手们可以更好地管理情绪,从而提高比赛中的操作精度。
2、团队协作与球员表现
团队协作是《eFootball™》手机组决赛中不可或缺的一环。在比赛中,球员之间默契配合能够显著提升整体表现,而这种协作需要长期磨合和沟通。各队伍通过不断调整阵容和角色分配来优化团队协作,以确保每位球员都能发挥出最佳水平。
相对而言,球员个人表现也是影响比赛结果的重要因素之一。优秀球员往往能够凭借个人能力在关键时刻做出决定性的贡献,这种表现不仅激励队友,也能改变比赛走势。因此,各队伍在备战过程中特别注重培养球员个人能力,以期在决赛中取得突破。
此外,数据结果显示出射门次数增加约25%,这表明球员们在进攻端表现更加积极。这一趋势为球队制定更具侵略性的进攻策略提供了依据,使得比赛节奏更加紧凑和激烈。通过合理利用数据分析,各队伍能够更好地调整战术,提高整体协作效率。
3、心理状态与环境因素
心理状态是影响《eFootball™》手机组决赛的重要因素之一。在高压环境下,选手们如何管理情绪将直接影响他们的操作精度和整体表现。为了帮助选手保持良好的心理状态,各队伍聘请了专业心理辅导员进行指导,通过心理训练来提高选手抗压能力。
这也意味着环境因素同样不可忽视。在东京举办的决赛为选手提供了先进的技术支持和舒适的比赛环境,这些都能有效缓解选手压力,提高他们在比赛中的专注力。此外,观众热情洋溢的氛围也为选手带来了额外动力,使他们能够更加投入地参与比赛。
整体而言,环境因素与心理状态密切相关,它们共同影响着选手在比赛中的表现。因此,各队伍在备战过程中不仅关注技术训练,还特别重视心理辅导和环境适应,以确保选手能够在最佳状态下迎接挑战。
教练思路是《eFootball™》手机组决赛中战略制炸金花游戏定的重要部分。教练们通过分析对手过往比赛录像来制定针对性策略,以期在比赛中占据优势。这种策略不仅需要考虑自身队伍特点,还需预测对手可能采取的行动,从而做出相应调整。
与此同时,对手应对策略也是各队伍备战的重要内容之一。在面对不同风格和特点的对手时,各队伍需要灵活调整阵容和战术,以应对不同挑战。这种灵活性要求教练具备敏锐洞察力和快速反应能力,以便及时做出有效决策。
此外,通过数据分析发现,对手防守成功率下降约30%,这为各队伍制定进攻策略提供了机会。教练们利用这一数据来优化进攻方案,使得球队能够更好地把握得分机会,从而提高胜利几率。这种基于数据分析的策略调整为球队带来了显著优势。
《eFootball™》手机组决赛以其激烈竞争和高水平技术展示吸引了全球电竞爱好者的目光。在东京举行的这场赛事不仅展示了各队伍卓越的技术水平,也体现了他们在团队协作、心理管理和战略制定上的努力与智慧。比赛结果显示出各队伍充分发挥了自身优势,在操作精度上取得了突破性进展,为观众奉献了一场精彩绝伦的电竞盛宴。
当前阶段,各队伍已进入赛事收尾阶段,通过总结经验和调整策略,他们将继续优化团队协作和个人表现,以迎接未来更多挑战。这场决赛不仅是对技术水平的一次检验,更是对团队精神和战略思维的一次深刻考验,为全球电竞赛事的发展提供了宝贵经验和启示。








